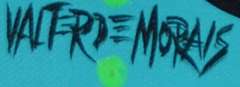

U.S. Auction Brokers: Find your next great deal on seized, confiscated, and foreclosed merchandise!
Morais Sweet Hug Original Acrylic
Artist: Valter de Morais
Title: Sweet Hug
Medium: Original Acrylic on Canvas
Signature: This one-of-a-kind work is hand-signed by the artist at the bottom of the image
Image Size: Approximately 20 inches x 20 inches
Framed: Gallery Wrapped Ready to Hang or Frame
Details: This work comes with a Certificate of Authenticity
Biography: Born and raised in Brazil, Valter Morais has been committed to the fine arts for most of his life. He graduated in fine arts by the University of Mogi das Cruzes, Sao Paulo, Brazil. He is represented in oil, acrylic, and watercolor in collections all over the world. He has shown in many nationally recognized shows in Brazil, New York, Kansas City, Las Vegas, Hawaii, Paris, Germany, Australia, England, Canada, and other major art centers. He has won award in several art shows including First Place, "World Peace by The United Nation." His "Portrait of Princess Anne" hangs in Buckingham Palace in London.
Certificate: This piece comes with a Certificate of Authenticity.